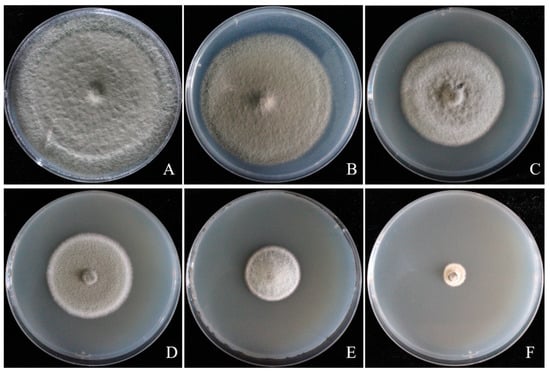

Abstract
Alternaria leaf blight has recently been described as an emerging fungal disease of apple trees which is causing the significant damage in the apple-growing areas of Tianshui and Jingning, Gansu, China. In the present study, the pathogen species involved in apple leaf blight and its biological characteristics were identified, and the inhibitory activity of different botanical fungicides against the pathogen was evaluated in vitro. Four strains were isolated from the symptomatic areas of necrotic apple leaves, and initially healthy leaves showed similar symptoms to those observed in orchards after inoculation with the ABL2 isolate. The ABL2 isolate was identified as Alternaria tenuissima based on the morphological characteristics of its colonies, conidiophores, and conidia, and this was also confirmed by multi-gene sequence (ITS, OPA10-2, Alta-1, and endoPG) analysis and phylogenic analysis. The optimum temperature, pH, carbon source, and nitrogen source for the growth of A. tenuissima mycelia were 28 °C, 6–7, soluble starch, and soy flour, respectively. In addition, the botanical fungicide eugenol exhibited the highest inhibitory effect on the mycelial growth and conidia germination of A. tenuissima, and the median effective concentration (EC50) values were 0.826 and 0.755 μg/mL, respectively. The protective and curative efficacy of eugenol were 86.85% and 76.94% after inoculation in detached apple leaves at a concentration of 4 μg/mL. Our research provides new insights into the control of apple leaf blight disease by applying botanical fungicides.
1. Introduction
Apples are one of the most widely cultivated and consumed fruits in the world and can look back on a history of cultivation spanning thousands of years [1]. The size of the areas undertaking the cultivation and output of apples in China has taken a leading position in the world in recent years [2] and is increasing year on year due to their high economic and nutritional value. However, apple leaf diseases can cause significant production and economic losses, as well as a decline in the quality and quantity of fruit production [3]. Alternaria leaf blotch, Marssonina leaf blotch, Glomerella leaf spot, and powdery mildew have been the most common and serious apple leaf diseases in recent years, and their causal pathogens have been identified as Alternaria mali, Marssonina coronaria, Glomerella cingulata, and Podosphaera leucotricha, respectively [4,5,6,7,8,9]. Alternaria leaf blotch is related to different taxa of Alternaria, which is prevalent in major apple-producing regions around the world [10,11]. In some susceptible varieties, Alternaria leaf blotch can cause up to 80% of early tree defoliation, which impairs the vitality of the trees and drastically reduces fruit yields [12,13,14]. Previous studies have shown that Alternaria spp. on apples mainly causes two different diseases: Alternaria leaf (fruit) spot and mildew core disease. Since 2019, we have discovered a new apple leaf disease in many apple-producing areas in Gansu Province, China. The symptoms of this disease differ from those previously reported for Alternaria leaf blotch. The pathogen of this disease spreads rapidly and has a higher virulence, leading to rapid drying and shedding of infected leaves within a short period, resulting in lower fruit quality and yield. However, the pathogen that causes this disease is still unknown.
Accurate identification of the pathogen of apple leaf blight is crucial for the epidemiology and management of the disease. Although the conidia of the genus Alternaria are distinct and easy to recognize, due to their highly similar morphological characteristics, many species of Alternaria have high isolate variability even within the same species [15,16,17]. The morphological characteristics of Alternaria species can change with the changes of environmental conditions [18]. Therefore, it is difficult to identify species of Alternaria based solely on morphology. Phylogenetic analysis based on polygenic loci has been used to identify Alternaria species as a useful supplement to morphological methods [19]. Several gene regions, such as the internal transcribed spacer (ITS), Alternaria major allergen 1 (Alta-1), endopolygalacturonase (endoPG), and anonymous noncoding gene region (OPA10-2), have proven useful in evaluating the phylogenetic interspecies relationships of Alternaria species [20].
Currently, synthetic fungicides are mainly used for the prevention and control of Alternaria leaf blotch disease in apples caused by Alternaria spp., and the effective synthetic agents are mainly tebuconazole, mancozeb, thiophanate methyl, carbendazim, and other fungicides [21]. However, a series of environmental problems and an increase in the risk of pathogen resistance have occurred due to the long-term use of synthetic fungicides, as well as an increase in production costs and a deterioration in fruit quality [22]. The development and use of environmentally friendly bio-fungicides has become a trend in the sustainable development of modern agriculture, with people’s increasing attention to environmental protection. Botanical fungicides have been used as alternative remedies to treat plant diseases due to their being effective, selective, biodegradable, and less toxic to the environment [23]. Plant extracts, essential oils, etc., are some of the botanical fungicides that have been shown to exert biological activity against plant fungal pathogens [24,25]. In recent years, many studies have reported on the antifungal activities of botanical fungicides or plant extracts against different plant Alternaria leaf blight pathogens, such as the botanicals of drake (Melia azedarach), which has a mycelial growth inhibition rate of 63.52% against Alternaria leaf blight of tomato caused by A. solani [26]. Methanolic leaf extracts of Elettaria cardamomum, Syzygium aromaticum, and Curcuma longa and root extract of Parthenium hysterophorus showed up to 100% inhibition of A. solani (potato) [27]. In sunflower, botanicals (Neem and Karanj) can significantly inhibit the growth of mycelia and disease intensity of Alternaria blight (A. helianthi) [28]. In contrast, few studies have focused on the antifungal activities of botanical fungicides against apple leaf diseases caused by Alternaria spp. [29].
There are few available data on the phenotypic characters and phylogenetic interspecies relationships of pathogen causing leaf blight disease on apples in China. In addition, understanding the biological characteristics of the pathogen and screening environmentally friendly fungicides may provide valuable data for formulating disease management strategies. Therefore, the purposes of this research were to: (i) isolate and identify the pathogen causing apple leaf blight in Gansu Province; (ii) determine the biological characteristics of the pathogen; (iii) assess the antifungal activity of five botanical fungicides against the pathogen.
2. Materials and Methods
2.1. Pathogen Isolation and Purification
One-hundred diseased apple (cultivars, ‘Fuji’ and ‘Gold Delicious’) leaf samples were collected from different locations in Gansu Province in August 2020 and 2021. Several pieces of the tissue at the intersection of disease and health of the diseased apple leaves (5 mm × 5 mm) were disinfected with 75% alcohol for 10 s and 1% sodium hypochlorite (NaOCl) for 3 min, and then rinsed with sterile water for three times. The sterilized leaf sections were dried on sterile filter paper and placed onto potato dextrose agar (PDA) plates (5 pieces per dish), and then the plates were incubated at 28 °C in the dark for 5 days. For each isolate, single-spore isolate was obtained from the sub-cultured fungal colonies using the dilution plate technique [30]. Purified single-spore isolates were obtained by sub-culturing three times on PDA at 28 °C with a light/dark (12/12 h) cycle for 5 days, and then stored at 4 °C for further study.
2.2. Pathogenicity Testing
Pathogenicity testing was conducted according to the method described by Li, et al. [31], with minimal modification. Healthy leaves of the same species of ‘Fuji’ were collected from Jingning, Gansu Province, and used for pathogenicity testing. Asymptomatic and similar-sized leaves were disinfected with 75% ethanol for 1 min, rinsed three times with sterile water, and air-dried. The surface and petiole of the leaves were wounded with sterile needles, and mycelial plugs (5 mm diameter) were taken from the margin of 5-day-old colonies of the isolates and inoculated on the wounds, respectively. Leaves inoculated with agar plugs of the same diameter served as the control. Twenty leaves were used for each isolate, and the test was repeated twice. The inoculated apple leaves were then kept at 28 °C with a 16 h/8 h light/dark cycle and 80% relative humidity for determining the pathogenicity of each isolate. The disease symptoms in the leaves were examined at 10 days after inoculation. Fungal pathogens were re-isolated from the symptomatic tissues of inoculated leaves and compared to the initial inoculation according to morphological characteristics.
2.3. Pathogen Identification
2.3.1. Morphological Observations
The morphological characteristics of ABL2 was recorded by inoculating on PDA plates with a light/dark cycle of 12/12 h at 28 °C for 5 days, and then the colony color and characteristics were recorded. The characteristics of conidiophore and conidia were observed by using a Nikon DS-Ri2 microscope, and the size of conidiophore and conidia were measured, each with 50 replications.
2.3.2. DNA Extraction, PCR Amplification
The genomic DNA of the ABL2 isolate was extracted using an E.Z.N.A. ® High Performance (HP) Fungal DNA Kit (OMEGA Bio-Tek, Norcross, GA, USA) and stored at -20°C. Four regions, the internal transcribed spacer (ITS), anonymous noncoding region (OPA10-2), Alternaria major allergen 1 (Alta-1), and endopolygalacturonase (endoPG), were used for the phylogenetic analysis of ABL2. The primers used in this study (Table 1) were synthesized by Sangon Biotech Co., Ltd. (Shanghai, China). Each polymerase chain reaction (PCR) contained (25 μL) 1 μL genomic DNA (50 ng), 10 μL of ddH2O, 1 μL of each primer (10 μM), and 12 μL of Taq PCR Mastermix (Tiangen Biotech, Beijing, China). PCR amplification was performed using an Eppendorf Mastercycler® Gradient PCR machine (Eppendorf Scientific, Hamburg, Germany). Amplification was performed using the following parameters: pre-denaturation at 94 °C for 4 min, followed by 30 cycles of denaturation at 94 °C for 30 s, annealing (Table 1), extension at 72 °C for 1 min, and a final extension at 72 °C for 10 min.

Table 1.
Characteristics of primer pairs used in this study for PCR assay.
2.3.3. Phylogenetic Analysis
The PCR products were sent to Sangon Biotech Co., Ltd. (Shanghai, China) for sequencing, and the obtained nucleotide sequences of ITS, Alta-1, endoPG, and OPA10-2 were deposited in GenBank with the accession numbers. The results were compared with BLAST sequences in the National Center for Biotechnology Information (NCBI) database. For phylogenetic analysis, the homologous Alternaria sequences were retrieved from GenBank using the BLASTn program and from a previous study [20] (Table S1). Sequences of each genetic region were aligned to the reference sequences in GenBank by using BioEdit 7.2.6.1 with manual adjustments. Multiple comparisons were performed using MAFF v7.037b software, while conservative region selection was performed using GBLOCKS 0.91b software. Aligned sequences of each of the three genes (Alta-1, endoPG, and OPA10-2) were combined using Sequence Matrix 1.7.8 software. Phylogenetic trees were constructed using combined sequences from the Clustal W 2.0 multiple alignment output using the GTRCAT nucleotide substitution model and maximum likelihood (ML) method in the MEGA X (version 10.1.7) software [35]. The bootstrap analyses were calculated using 1000 replicates under the same model. The phylogenetic tree was edited and visualized using the online tool tvBOT [36].
2.4. Biological Characteristics
2.4.1. Effect of Different Carbon and Nitrogen Sources on Mycelial Growth of the ABL2 Isolate
The medium of Czapek Dox Agar (30 g/L of sucrose, 0.5 g/L of MgSO4·7H2O, 0.5 g/L of KCl, 3 g/L of NaNO3, 0.01 g/L of FeSO4, 1 g/L of KH2PO4, 15 g/L of agar, initial pH value is 6.5) served as base medium for determining the effect of different carbon and nitrogen sources on ABL2 mycelial growth. Sucrose, maltose, fructose, mannitol, dextrose, and soluble starch were selected as the sole carbon sources to replace the carbon source (sucrose) in the Czapek medium with the same amount of addition; soy flour, ammonium nitrate, beef extract, sodium nitrate, peptone, and yeast extract were selected as the sole nitrogen sources to replace the nitrogen source (sucrose) in the Czapek medium with the same addition amount. Mycelial plugs (5 mm diameter) from the margins of 5-day-old ABL2 colonies on PDA were transferred to media with different carbon and nitrogen sources. Each treatment was then placed in an incubator at 28 °C in the dark. The growth of ABL2 was evaluated after 7 days by measuring the colony diameter of each treatment (minus the diameter of the inoculation plug). There were three replicates in each treatment, and the experiment was performed three times.
2.4.2. Effects of Light Regime, Temperature and Different pH on Mycelial Growth of the ABL2 Isolate
Mycelial plugs (5 mm diameter) from ABL2 the edge of 5-day-old colonies were placed on PDA plates and incubated at 28 °C. The light period was set as follows: full dark, full light, or 12/12 h light/dark. To study the effect of temperature on the radial growth of ABL2, the inoculated PDA plates were placed in the dark at 5 °C, 10 °C, 20 °C, 25 °C, 28 °C, 30 °C, and 35 °C.
The PDA medium was adjusted to a desired pH value ranging from 3 to 12 in increments of one by using HCl or NaOH (Sigma Chemical Co., St. Louis, MO, USA). The mycelial plugs (5 mm diameter) of each 5-day-old colony were transferred to the center of PDA plates with different pH values and incubated at 28 °C in the dark.
Each treatment with a specific light exposure time, pH value, and temperature was replicated three times, with each PDA plate considered a replicate. After being inoculated for 7 days at different conditions, the colony diameters (minus the diameter of the inoculation plug) were measured and recorded. Each experiment was repeated three times.
2.5. Efficacy of Different Botanical Fungicides against the Mycelial Growth of the ABL2 Isolate
Five commercial formulations botanical fungicides, matrine (Tianjin Hengyuan Weiye Biotechnology Development Co., Ltd., Tianjin, China), eugenol (Shandong Yijia Chemical Technology Co., Ltd., Zaozhuang, China), carvacrol (Lanzhou Shichuang Biotechnology Co., Ltd., Lanzhou, China), ethylicin (Kaifeng Dadi Agrochemical Biotechnology Co., Ltd., Kaifeng, China), and berberine (Hebei Wante Biochemistry Co., Ltd., Shijiazhuang, China), as well as a synthetic fungicide dithianon + pyraclostrobin (Qingdao Star Cropscience Co., Ltd., Qingdao, China), were applied in the present experiment for determining their efficacy against the mycelial growth of ABL2. The concentrations of five botanical fungicides and one synthetic fungicide are listed in Table 2. Mycelial plugs (5 mm diameter) from the margin of 5-day-old colonies of ABL2 were transferred to PDA plates containing different concentrations of fungicides. The colony diameters (minus the diameter of the inoculation plug) were measured by measuring the average diameter in two perpendicular directions at 7 days after incubation at 28 °C PDA plates without fungicide (negative control) and PDA plates with different concentrations of dithianon + pyraclostrobin (positive control) were used as the control. Antifungal activity was expressed in terms of percentage of mycelial growth inhibition (MGI) and calculated according to the following formula: MGI% = [(a − b)/a] × 100, where a is ABL2 colony diameter of the negative control and b is ABL2 colony diameter in the presence of the fungicides.

Table 2.
Different fungicides and diluted concentrations.
The EC50 (the concentration which reduced mycelial growth by 50%) values were calculated by regressing the inhibition of radial growth values (%control) against the log10 values of the fungicide concentrations [37,38]. These were performed with three replicates per concentration of each agent, and the experiment was performed three times.
2.6. Efficacy of Different Botanical Fungicides against ABL2 Spore Germination
For the determination the efficacy of different botanical fungicides against spore germination, a spore suspension of ABL2 was prepared at the concentration of 106 spores/mL after incubation for 7 days on PDA. Then, 40 μL of spore suspension was transferred to sterile slides containing 40 μL of Malt Extract Broth (MEB) with different concentrations of fungicides (Table 2). The MEB supplemented with the same amount of sterile distilled water (negative control) and different concentrations of dithianon + pyraclostrobin (positive control) were used as the controls. Thereafter, the sterile slides were placed on moist filter paper in Petri plates, and incubated at 25 °C for 8 h in dark. The number of spores germinated were determined under microscope using a micrometer. The spore germination rates were recorded when the length of a germ tube was equal to or more than half of the diameter of a spore. The experiment was repeated three times and at least 100 spores of each replicate were observed.
The efficacy of different botanical fungicides inhibited the spore germination were expressed as percent spore germination inhibition (GI) and calculated using the following equation: GI (%) = [(Gc − Gt)/Gc)] × 100, where Gc represents the average spore germination number of the control and Gt represents the average spore germination number treated with the fungicide. The EC50 values for ABL2 isolate was calculated by regressing percentage spore germination inhibition against the log10 of fungicide concentration.
2.7. Protective and Curative Activity of Eugenol on Detached Apple Leaves
The protective and curative activity of eugenol on apple leaves was determined according to Duan, et al. [39], with some modifications. The surface of healthy apple leaves of the ‘Fuji’ variety was disinfected with 75% ethanol for 1 min, washed with sterile water three times, and then the excess water was removed by sterile filter paper. The soluble eugenol concentrate was diluted to 4 μg/mL with sterile water containing 0.1% Tween 80. The leaf age, growth position, and size of all treatments were similar. For the protective activity assay, the surface and petiole of apple leaves were wounded with a sterilized needle, avoiding the midrib, and sprayed with eugenol (4 μg/mL) until liquid flowed onto the surface. After 24 h, the mycelial plugs (5 mm in diameter) were inoculated from the 5-day-old colony of the ABL2 isolate. For the curative effect assay, the leaves were sprayed with eugenol 24 h after inoculation with the mycelial plugs of ABL2 isolate. Sterile water containing 0.1% Tween 80 was sprayed instead of eugenol as the control. The inoculated apple leaves were then placed at 28°C and 80% RH, under a 16 h photoperiod for disease development. Photos were taken to record the disease status of the leaves, analyze the damage area of the leaves using ImageJ software (version 1.8.0) (http://rsb.info.nih.gov/ij/, accessed on 22 October 2022.) after 10 days, and calculate the disease severity based on the area of lesions on each leaf; the formula is as follows: Disease severity (%) = (Infected tissue area)/(Total tissue area) × 100. The experiment was performed twice with twenty leaves per treatment.
2.8. Statistical Data Analysis
Unless otherwise specified, all experiments were conducted at least three times, with three replicates for each treatment. Data are expressed as mean ± SD (standard deviation). Statistical analyses were performed using the SPSS version 26.0 (SPSS Inc., Chicago, IL, USA). All data were tested for normally distributed data and homogeneity of variance before post hoc testing. Differences between different treatments were tested post hoc using Duncan’s multiple comparisons.
3. Results
3.1. Field Symptoms of Apple Leaf Blight
During the period of July to October of 2020, apple leaf blight disease was observed on the foliage in several apple orchards (‘Fuji’ and ‘Golden Delicious’) in Pingliang and Tianshui City, Gansu Province. At the initial stage, brownish lesions appear on the petiole in ‘Fuji’ (Figure 1A) and ‘Golden Delicious’ (Figure 1D), and then spread from the petiole along the leaf margin to the inside of the leaf, forming stripes or irregular shapes of lesions (Figure 1B,C,E). As the disease progresses, the lesions rapidly expand inward along the leaf margin to the entire leaf, causing the leaf to dry up and easily fall off (Figure 1E). A grayish black mold layer appears on the lesions on the back of the leaf under high humidity (Figure 1F). The disease generally began in early June and peaked in July and August, causing a large number of premature defoliations of apple trees and ultimately a decline in apple production.

Figure 1.
Field disease symptoms of apple leaves. (A–C) represent the symptoms of leaf blight on the petiole, leaf front, and leaf back of ‘Fuji’. (D–F) represent the symptoms of leaf blight on the petiole, leaf front, and leaf back of ‘Golden Delicious’, respectively.
3.2. Pathogen Isolation and Pathogenicity Testing
Eighty-five isolates were isolated from the collected samples of ‘Fuji’ leaves (80) and ‘Golden Delicious’ leaves (20), which were classified into four types. Among them, Alternaria spp. was the dominant type, with a total of 73 isolates. The Alternaria species were primary classified as ABL1 (4 isolates from ‘Fuji’ and 2 isolates from ‘Golden Delicious’), ABL2 (48 isolates from ‘Fuji’ and 8 isolates from ‘Golden Delicious’), ABL3 (3 isolates from ‘Fuji’), and ABL4 (5 isolates from ‘Fuji’ and 3 isolates from ‘Golden Delicious’) according to the colonies and conidial morphology. The pathogenicity of four types of isolates was determined by needle-puncture method. The results showed that 10 days after inoculating ABL2, apple leaves developed lesions with symptoms similar to those initially observed in the field (Figure 2A), while control leaves remained healthy (Figure 2B). The fungus was re-isolated from diseased leaf tissue using the above method, and microscopic observation showed that its colony morphology and conidial structure were similar to ABL2. However, no obvious symptoms appeared after inoculation with the other types of isolates. The isolate ABL2 was determined to be the causal agent of apple leaf blight according to Koch’s postulates.

Figure 2.
The symptoms of apple leaf blight caused by artificial inoculation. (A) Infected symptoms on detached wounded leaves of apple cultivar ‘Fuji’ 10 days after artificial infection with ABL2; (B) inoculated with PDA plugs (control).
3.3. Morphological Characteristics of Cultures and Sporulation
The colonies in the pre-growth stage of ABL2 on PDA were grayish white; in the later stages, the color of the colony center gradually deepened to green, the shape was slightly convex, the surface hyphae was dense and tapered, the edges were neat, and the hyphal layer was thick (Figure 3A,B). Conidiophores solitary or terminally erecting from hyphae, slightly curved, pale brown to brown, commonly 10 to 60 × 4 to 6 μm with 1–5 septa (Figure 3D). The conidia had smooth surfaces, were brown or dark brown, typically obclavate or club-shaped, multi-septate, and had 1–5 transverse septa and 0~3 longitudinal septa (Figure 3C). Conidia ranged from 7.5 to 32.6 × 3.10 to 15.71 μm in size (n = 50).

Figure 3.
Morphological characteristics of Alternaria isolate ABL2 on PDA. (A) Colony front on PDA medium; (B) Colony reverse on PDA medium; (C) Conidia; (D) Conidiophore.
3.4. Molecular Identification
The genomic DNA of ABL2 was extracted and used as a template. The PCR product sequence of the isolate have been submitted to GenBank (accession numbers: MZ150772 for ITS, MZ222271 for Alta-1, MZ222269 for endoPG, and MZ222272 for OPA10-2). The ITS sequence of ABL2 were BLASTn similarity aligned in NCBI, and the online alignment results showed that the sequences of the isolate ABL2 had more than 99.30% identity for A. tenuissima and A. alternata (MN856355, MN822659, MH447270.1, et al.), but the species of Alternaria could not be confirmed by the sequence of ITS. The Alta-1 gene region sequence of A. tenuissima was 99.41% similar to the reference sequences (accession numbers: MW016006). The regional sequence of endoPG was compared with the reference sequence of A. tenuissima in GenBank, and the results showed 99.79% similarity with the reference sequence (accession numbers: MW016002). The OPA10-2 gene region sequence had 100% similarity with reference sequence of the same species (accession numbers EF503988).
The three genes of Alta-1, endoPG, and OPA10-2 were connected in series by SequenceMatrix 1.7.8 software in the following order: Alta-1, endoPG, and OPA10-2. The phylogenetic analysis was conducted for the combined data set by ML. The results indicated that the sequence of each gene of isolate ABL2 was identical to Alternaria tenuissima, and they were grouped together with a bootstrap value of 1 (Figure 4). Combined with the morphological characteristics of the pathogenic isolate ABL2, the pathogen was finally identified as A. tenuissima.

Figure 4.
Maximum likelihood (ML) phylogram of the present Alternaria isolate ABL2 (red words) based on combined Alta-1, endoPG, and OPA10-2 genes sequence. Alternaria iridiaustralis CBS 118486 was selected as outgroup. Colors indicate clades seen on the concatenated phylogram of the three loci. The numbers beside all branches represent bootstrap values generated from 1000 replicates.
3.5. Biological Characteristics
Different carbon sources, nitrogen sources, pH, and temperatures have varying degrees of influence on the mycelial growth of A. tenuissima ABL2. After inoculating on different carbon source media for 7 days, colony morphology and diameter were observed and measured. The results showed that the pathogen grew fastest on the soluble starch medium, with a diameter of 69.46 mm and thick, light brown colonies, which was a significant difference from the other carbon sources. The growth rate was the slowest on the mannitol medium, with a colony diameter of 31.08 mm and thin, milky white colonies (Figure 5A). The pathogen grew faster on soy flour, peptone, and beef extract after being cultured on different nitrogen media for 7 days. The mycelia of ABL2 grew fastest when soy flour was used as the nitrogen source, and the colonies were thick and dark brown with a diameter of 77.28 mm. The mycelia grew slowly when yeast extract was used as the nitrogen source (Figure 5B). The results showed that ABL2 had the highest utilization rates of soluble starch and soy flour.

Figure 5.
Effects of carbon source (A), nitrogen source (B), temperature (C) and pH (D) on the mycelial growth of A. tenuissima ABL2. Effect of carbon source on the mycelial growth of A. tenuissima ABL2. Bars represent the standard deviations of the means. Means followed by the different letters on the top of each column are significantly different at the p < 0.05 level of confidence according to Duncan’s multiple range test.
There was no significant difference in colony growth of ABL2 under different light treatments after 7 days. Under different temperature conditions, the pathogen mycelia could grow at 5–35 °C, and the optimum temperature was 25–30 °C. The colony diameter was the largest at 28 °C, with an average diameter of 85.00 mm, which was significantly higher than under other temperature conditions (Figure 5C). The mycelia of ABL2 could grow at pH 3–10, and the average colony diameter was the largest, with 82.38 mm at pH 7, which was significantly different from the other treatments (Figure 5D). In conclusion, the optimum growth temperature of A. tenuissima ABL2 was 28 °C and the optimum pH was 7.
3.6. Botanical Fungicides Sensitivity of A. tenuissima ABL2
3.6.1. Inhibitory Effects of Different Botanical Fungicides on the Mycelial Growth of A. tenuissima ABL2
Different botanical fungicides had significant antifungal activity on A. tenuissima ABL2. Eugenol and carvacrol showed significantly higher inhibitory activity against ABL2 than the chemical fungicide pyraclostrobin + dithianon esters and other botanical fungicides, among which eugenol showed the best inhibitory effect, with an EC50 value of 0.826 μg/mL, followed by matrine with an EC50 of 4.383 μg/mL, and pyraclostrobin + dithianon with an EC50 of 16.702 µg/mL. The inhibition effects of eugenol on mycelial growth of ABL2 at a series of concentrations of 0.4, 0.8, 1.6, 3.2, and 6.4 μg/mL are shown in Figure 6. Ethylicin and berberine showed lower inhibitory activity against ABL2 than the chemical fungicide pyraclostrobin + dithianon, in which carvacrol and ethylicin’s EC50 values were 13.655 µg/mL and 20.948 μg/mL, respectively, and berberine showed a weak inhibitory effect with an EC50 value of 41.767 μg/mL (Table 3).
Figure 6.
Inhibitory effect of eugenol with different concentrations on Alternaria tenuissima ABL2. (A) CK; (B) 0.4 μg/mL; (C) 0.8 μg/mL; (D) 1.6 μg/mL; (E) 3.2 μg/mL; (F) 6.4 μg/mL.

Table 3.
Inhibitory effects of different botanical fungicides on the colony growth of Alternaria tenuissima ABL2.
3.6.2. Inhibitory Effects of Different Botanical Fungicides on Spore Germination of the A. tenuissima ABL2
Spore germination of A. tenuissima ABL2 was inhibited by different concentrations of the fungicides. An increase in the fungicide concentrations increased the inhibition rate. Among the five fungicides, eugenol and matrine showed the highest inhibition rates, with EC50 values of 0.755 μg/mL and 6.352 μg/mL, respectively, as well as pyraclostrobin + dithianon with an EC50 value of 15.366 μg/mL. Carvacrol and ethylicin had inhibition effects on the spore germination of ABL2, with EC50 values of 20.109 μg/mL and 27.259 μg/mL. Berberine also showed an inhibition effect, with an EC50 value of 40.096 μg/mL (Table 4).

Table 4.
Effects of different botanical fungicides on the spore germination of Alternaria tenuissima ABL2.
3.7. Protective and Curative Activity of Eugenol
The protective and curative activity of eugenol against A. tenuissima ABL2 on detached apple leaves was determined. The results showed that eugenol exhibited both protective and curative activity on apple leaves. In protective activity assay, with application of eugenol at 4 μg/mL, the disease severity only reached 11.70%, and the control efficacy reached 86.85%. In the curative activity assay, after application of eugenol the disease severity was 21.03%, and the control efficacy reached 76.94% (Table 5, Figure 7). In the same concentration, the protective activity of eugenol against A. tenuissima ABL2 was better than its curative activity.

Table 5.
Protective and curative activity of eugenol against A. tenuissima ABL2 on leaves of apple.

Figure 7.
Protective and curative activity of eugenol against A. tenuissima ABL2 on apple leaves. (A) Protective activity; (B) Curative activity.
4. Discussion
In the current study, the Alternaria spp. responsible for leaf blight of apple was identified using both molecular and morphological methods. Our study provided evidence that the leaf blight pathogens on apple leaves in Gansu Province of China were all associated with Alternaria. From our findings, ABL2 was identified as the main pathogen of apple leaf blight following a pathogenicity test. Morphological and phylogenetic analysis of the ITS, OPA10-2, Alta-1, and endoPG gene sequences showed that ABL2 was A. tenuissima. Conidial length and width were two morphological characteristics used for species differentiation [40]. The conidia sizes observed in our study matched the dimensions (4.8 to 15.7 μm in width and 7.1 to 31.8 μm in length) previously described by Zhang, et al. [41]. A clear separation of species was obtained in the combined phylogeny based on the OPA10-2, Alta-1, and endoPG sequences. For Alternaria-caused leaf spot disease of apple trees, A. alternata Apple Pathotype has been identified as the causal agent of Alternaria leaf spot disease in Japan, China, and the United State [22]. Compared with A. alternata, A. tenuissima occurs more rapidly and severely, causing a large proportion of apple leaves to wither and drop in a short time, which is why it is called Alternaria leaf blight. It has been reported that A. tenuissima could infect a variety of plants and cause the occurrence of leaf blight, such as Citrullus lanatus [42], Helianthus annuus [43], Zea mays [44], Saccharum officinarum [45], etc. Harteveld, et al. [14] found that leaf spot disease and fruit spot disease of apples caused by Alternaria species occur in apple orchards in Australia, and that the Alternaria species causing these two diseases are mainly A. arborescens (47%), A. alternata/A. tenuissima (14%), and A. tenuissima/A. mali (6%), but leaf blight disease of apples caused by A. tenuissima was first discovered in China.
Nutrient media with different carbon and nitrogen sources, pH, and temperature can affect the mycelial growth and virulence of pathogenic fungi [17,46], so it is helpful to clarify the biological characteristics of pathogens to better understand the field incidence of diseases. In this study, the optimal carbon, nitrogen source, temperature and pH for A. tenuissima were soluble starch, soybean flour, 28 °C and 7. The results of the biological characterization of A. tenuissima showed that the disease is more likely to outbreak in warm, humid seasons, which is consistent with the law of pathogenesis of apple blight in our study.
Disease control strategies that have been investigated as alternatives to currently used fungicides to control plant diseases caused by A. tenuissima generally include the use of new fungicides, antagonistic microorganisms [47], and plant extracts [48,49]. Although application of fungicide is still the main method for control of apple tree diseases, continuous and extensive use of a single chemical may lead to undesirable effects such as environmental pollution, residue toxicity, and the risk of fungicide resistance. Botanical fungicides are becoming more popular due to their specific antifungal activity, ease of degradation, and safety to humans. In recent years, several studies have focused on screening plant extracts to develop new antifungal botanical fungicides that can be used to control apple tree diseases [50,51]. In this study, eugenol showed excellent ability to inhibit Alternaria hyphal growth and spore germination compared to the synthetic control fungicide. However, indoor research conditions are relatively stable, while uncontrollable environmental factors may exist in the field. Therefore, whether this agent can be used effectively and stably in the field needs further experimental investigation. To the best of our knowledge, our study provides the first report on the identification of A. tenuissima as the causal agent of apple leaf blight in Gansu Province, China.
5. Conclusions
The current study demonstrated that apple leaf blight in apple-producing regions in Gansu Province, China, is associated with isolates of A. tenuissima. Carbon sources, nitrogen sources, temperature, and pH were experimentally confirmed to be essential for the growth of A. tenuissima ABL2. Furthermore, our results showed that eugenol could be considered as a beneficial biocontrol agent in controlling apple leaf blight. Future research will focus on whether eugenol has the ability to protect against A. tenuissima throughout the whole disease cycle under different environmental conditions in the field.
Supplementary Materials
The following supporting information can be downloaded at: https://www.mdpi.com/article/10.3390/jof10040255/s1, Table S1: Reference sequences, species, sources, and GenBank accession numbers used for phylogenetic analysis in the study.
Author Contributions
Conceptualization, S.Z. and B.X.; methodology, E.L., J.L., S.Z. and B.X.; data curation, E.L.; software, E.L.; validation, E.L.; resources, S.Z., B.X. and J.L.; funding acquisition, S.Z.; project administration, S.Z. and B.X.; supervision, S.Z., B.X. and J.L.; writing—original draft preparation, E.L.; visualization, E.L. and S.Z.; writing—review and editing, S.Z. and B.X. All authors have read and agreed to the published version of the manuscript.
Funding
This work was supported by the Key R & D Project in Gansu Province (project 23YFNA0020); Major science and technology projects of Gansu Province (project 22ZD6NA045); Fuxi Outstanding Talent Cultivation Program, Gansu Agricultural University (project Gaufx-03J03); Lanzhou Science and Technology Plan Project (2021-1-39).
Institutional Review Board Statement
Not applicable.
Informed Consent Statement
Not applicable.
Data Availability Statement
The data in this study are available on request from the corresponding author/first author.
Conflicts of Interest
The authors declare no conflicts of interest.
References
- Li, Y.; Aldwinckle, H.S.; Sutton, T.; Tsuge, T.; Kang, G.; Cong, P.H.; Cheng, Z.M. Interactions of apple and the Alternaria alternata apple pathotype. Crit. Rev. Plant Sci. 2013, 32, 141–150. [Google Scholar] [CrossRef]
- Wang, N.; Wolf, J.; Zhang, F.S. Towards sustainable intensification of apple production in China—Yield gaps and nutrient use efficiency in apple farming systems. J. Integr. Agric. 2016, 15, 716–725. [Google Scholar] [CrossRef]
- Zhong, Y.; Zhao, M. Research on deep learning in apple leaf disease recognition. Comput. Electron. Agric. 2020, 168, 105146. [Google Scholar] [CrossRef]
- Lee, D.H.; Back, C.G.; Win, N.K.; Choi, K.H.; Kim, K.M.; Kang, I.K.; Choi, C.; Yoon, T.M.; Uhm, J.Y.; Jung, H.Y. Biological characterization of Marssonina coronaria associated with apple blotch disease. Mycobiology 2011, 39, 200–205. [Google Scholar] [CrossRef]
- Zhang, Y.; Shi, X.; Li, B.; Zhang, Q.; Liang, W.; Wang, C. Salicylic acid confers enhanced resistance to Glomerella leaf spot in apple. Plant Physiol. Biochem. 2016, 106, 64–72. [Google Scholar] [CrossRef]
- Abe, K.; Iwanami, H.; Kotoda, N.; Moriya, S.; Takahashi, S. Evaluation of apple genotypes and Malus species for resistance to Alternaria blotch caused by Alternaria alternata apple pathotype using detached-leaf method. Plant Breed. 2010, 129, 208–218. [Google Scholar] [CrossRef]
- Wang, C.X.; Zhang, Z.F.; Li, B.H.; Wang, H.Y.; Dong, X.L. First report of Glomerella leaf spot of apple caused by Glomerella cingulata in China. Plant Dis. 2012, 96, 912. [Google Scholar] [CrossRef]
- Khodadadi, F.; Martin, P.L.; Donahue, D.J.; Peter, K.A.; Aćimović, S.G. Characterizations of an emerging disease: Apple blotch caused by Diplocarpon coronariae (syn. Marssonina coronaria) in the Mid-Atlantic United States. Plant Dis. 2022, 106, 1803–1817. [Google Scholar] [CrossRef]
- Saito, A.; Nakazawa, N.; Suzuki, M. Selection of mutants resistant to Alternaria blotch from in vitro -cultured apple shoots irradiated with X- and γ-rays. J. Plant Physiol. 2001, 158, 391–400. [Google Scholar] [CrossRef]
- Armitage, A.D.; Barbara, D.J.; Harrison, R.J.; Lane, C.R.; Sreenivasaprasad, S.; Woodhall, J.W.; Clarkson, J.P. Discrete lineages within Alternaria alternata species group: Identification using new highly variable loci and support from morphological characters. Fungal Biol. 2015, 119, 994–1006. [Google Scholar] [CrossRef]
- Gur, L.; Reuveni, M.; Cohen, Y. Occurrence and etiology of Alternaria leaf blotch and fruit spot of apple caused by Alternaria alternata f. sp. mali on cv. Pink lady in Israel. Eur. J. Plant Pathol. 2017, 147, 695–708. [Google Scholar] [CrossRef]
- Filajdić, N.; Sutton, T. Identification and distribution of Alternaria mali on apples in North Carolina and susceptibility of different varieties of apples to Alternaria blotch. Plant Dis. 1991, 75, 1045–1048. [Google Scholar] [CrossRef]
- Rotondo, F.; Collina, M.; Brunelli, A.; Pryor, B.M. Comparison of Alternaria spp. collected in Italy from apple with A. mali and other AM-Toxin producing strains. Phytopathology 2012, 102, 1130–1142. [Google Scholar] [CrossRef]
- Harteveld, D.O.C.; Akinsanmi, O.A.; Drenth, A. Multiple Alternaria species groups are associated with leaf blotch and fruit spot diseases of apple in Australia. Plant Pathol. 2013, 62, 289–297. [Google Scholar] [CrossRef]
- Lawrence, D.P.; Gannibal, P.B.; Dugan, F.M.; Pryor, B.M. Characterization of Alternaria isolates from the infectoria species-group and a new taxon from Arrhenatherum, Pseudoalternaria arrhenatheria sp. nov. Mycol. Prog. 2014, 13, 257–276. [Google Scholar] [CrossRef]
- Pryor, B.M.; Michailides, T.J. Morphological, pathogenic, and molecular characterization of Alternaria isolates associated with Alternaria late blight of pistachio. Phytopathology 2002, 92, 406–416. [Google Scholar] [CrossRef]
- Blagojević, J.; Vukojević, J.; Ivanović, B.; Ivanović, Ž. Characterization of Alternaria species associated with leaf spot disease of Armoracia rusticana in Serbia. Plant Dis. 2020, 104, 1378–1389. [Google Scholar] [CrossRef] [PubMed]
- Marin-Felix, Y.; Hernández-Restrepo, M.; Iturrieta-González, I.; García, D.; Gené, J.; Groenewald, J.Z.; Cai, L.; Chen, Q.; Quaedvlieg, W.; Schumacher, R.K.; et al. Genera of phytopathogenic fungi: GOPHY 3. Stud. Mycol. 2019, 94, 1–124. [Google Scholar] [CrossRef]
- Woudenberg, J.H.C.; Groenewald, J.Z.; Binder, M.; Crous, P.W. Alternaria redefined. Stud. Mycol. 2013, 75, 171–212. [Google Scholar] [CrossRef]
- Woudenberg, J.H.; Seidl, M.F.; Groenewald, J.Z.; de Vries, M.; Stielow, J.B.; Thomma, B.P.; Crous, P.W. Alternaria section Alternaria: Species, formae speciales or pathotypes? Stud. Mycol. 2015, 82, 1–21. [Google Scholar] [CrossRef]
- Filajdic, N.; Sutton, T. Chemical control of Alternaria blotch of apples caused by Alternaria mali. Plant Dis. 1992, 76, 126–130. [Google Scholar] [CrossRef]
- Li, Y.; Zhang, L.; Zhang, Z.; Cong, P.; Cheng, Z.-M. A simple sequence repeat marker linked to the susceptibility of apple to Alternaria blotch caused by Alternaria alternata apple pathotype. J. Amer. Soc. Hort. Sci. 2011, 136, 109–115. [Google Scholar] [CrossRef]
- Zaker, M. Natural plant products as eco-friendly fungicides for plant diseases control—A review. Agriculturists 2016, 14, 134–141. [Google Scholar] [CrossRef]
- Romanazzi, G.; Lichter, A.; Gabler, F.M.; Smilanick, J.L. Recent advances on the use of natural and safe alternatives to conventional methods to control postharvest gray mold of table grapes. Postharvest Biol. Technol. 2012, 63, 141–147. [Google Scholar] [CrossRef]
- Ferraz, C.A.; Pastorinho, M.R.; Palmeira-de-Oliveira, A.; Sousa, A.C.A. Ecotoxicity of plant extracts and essential oils: A review. Environ. Pollut. 2022, 292, 118319. [Google Scholar] [CrossRef]
- Kumar, V.; Singh, G.; Tyagi, A. Evaluation of Different fungicides against Alternaria leaf blight of tomato (Alternaria solani). Int. J. Curr. Microbiol. Appl. Sci. 2017, 6, 2343–2350. [Google Scholar] [CrossRef]
- Sarfraz, M.; Khan, S.; Moosa, A.; Farzand, A.; Ishaq, U.; Naeem, I.; Khan, W. Promising antifungal potential of selective botanical extracts, fungicides and Trichoderma isolates against Alternaria solani. Cercet. Agron. Mold. 2018, 51, 65–74. [Google Scholar] [CrossRef]
- Waghe, K.; Wagh, S.; Kuldhar, D.; Pawar, D. Evaluation of different fungicides, bioagents and botanicals against Alternaria blight caused by Alternaria helianthi (Hansf) of sunflower. Afr. J. Agric. Res. 2015, 10, 351–358. [Google Scholar] [CrossRef][Green Version]
- Jung, K.H. Growth inhibition effect of pyroligneous acid on pathogenic fungus, Alternaria mali, the agent of Alternaria blotch of apple. Biotechnol. Bioprocess Eng. 2007, 12, 318–322. [Google Scholar] [CrossRef]
- Thangavelu, R.; Mostert, D.; Gopi, M.; Devi, P.G.; Padmanaban, B.; Molina, A.B.; Viljoen, A. First detection of Fusarium oxysporum f. sp. cubense tropical race 4 (TR4) on Cavendish banana in India. Eur. J. Plant Pathol. 2019, 154, 777–786. [Google Scholar] [CrossRef]
- Li, L.; Pan, H.; Deng, L.; Wang, Z.P.; Li, D.W.; Zhang, Q.; Chen, M.Y.; Zhong, C.H. First Report of Alternaria tenuissima causing brown spot disease of kiwifruit foliage in China. Plant Dis. 2018, 103, 582. [Google Scholar] [CrossRef]
- White, T.J.; Bruns, T.; Lee, S.; Taylor, J. Amplification and direct sequencing of fungal ribosomal RNA genes for phylogenetics. In PCR protocols: A Guide to Methods and Applications; Wiley: Hoboken, NJ, USA, 1990; Volume 18, pp. 315–322. [Google Scholar]
- Andrew, M.; Peever, T.L.; Pryor, B.M. An expanded multilocus phylogeny does not resolve morphological species within the small-spored Alternaria species complex. Mycologia 2009, 101, 95–109. [Google Scholar] [CrossRef]
- Hong, S.G.; Cramer, R.A.; Lawrence, C.B.; Pryor, B.M. Alt a 1 allergen homologs from Alternaria and related taxa: Analysis of phylogenetic content and secondary structure. Fungal Genet. Biol. 2005, 42, 119–129. [Google Scholar] [CrossRef]
- Kumar, S.; Stecher, G.; Li, M.; Knyaz, C.; Tamura, K. MEGA X: Molecular evolutionary genetics analysis across computing platforms. Mol. Biol. Evol. 2018, 35, 1547–1549. [Google Scholar] [CrossRef]
- Xie, J.; Chen, Y.; Cai, G.; Cai, R.; Hu, Z.; Wang, H. Tree Visualization By One Table (tvBOT): A web application for visualizing, modifying and annotating phylogenetic trees. Nucleic Acids Res. 2023, 51, W587–W592. [Google Scholar] [CrossRef]
- Iacomi-Vasilescu, B.; Avenot, H.; Bataille-Simoneau, N.; Laurent, E.; Guénard, M.; Simoneau, P. In vitro fungicide sensitivity of Alternaria species pathogenic to crucifers and identification of Alternaria brassicicola field isolates highly resistant to both dicarboximides and phenylpyrroles. Crop Prot. 2004, 23, 481–488. [Google Scholar] [CrossRef]
- Kuang, J.; Hou, Y.P.; Wang, J.-X.; Zhou, M.G. Sensitivity of Sclerotinia sclerotiorum to fludioxonil: In vitro determination of baseline sensitivity and resistance risk. Crop Prot. 2011, 30, 876–882. [Google Scholar] [CrossRef]
- Duan, Y.; Ge, C.; Liu, S.; Chen, C.; Zhou, M. Effect of phenylpyrrole fungicide fludioxonil on morphological and physiological characteristics of Sclerotinia sclerotiorum. Pestic. Biochem. Physiol. 2013, 106, 61–67. [Google Scholar] [CrossRef]
- Troncoso-Rojas, R.; Tiznado-Hernández, M.E. Chapter 5-Alternaria alternata (Black Rot, Black Spot). In Postharvest Decay; Academic Press: Cambridge, MA, USA, 2014; pp. 147–187. [Google Scholar] [CrossRef]
- Zhang, X.; Jiang, B.W.; Wang, R.T.; Li, Y.G.; Sun, L. Occurrence of leaf spot of begonia semperflorens caused by Alternaria tenuissima in China. Plant Dis. 2020, 104, 2292. [Google Scholar] [CrossRef]
- Ma, G.; Zhang, X.; Hua, H.; Zhou, T.; Wu, X. Molecular and biological characterization of a novel strain of Alternaria alternata chrysovirus 1 identified from the pathogen Alternaria tenuissima causing watermelon leaf blight. Virus Res. 2020, 280, 197904. [Google Scholar] [CrossRef] [PubMed]
- Wang, T.; Zhao, J.; Ma, G.; Bao, S.; Wu, X. Leaf blight of sunflower caused by Alternaria tenuissima and A. alternata in Beijing, China. Can. J. Plant Pathol. 2019, 41, 372–378. [Google Scholar] [CrossRef]
- Xu, X.; Zhang, L.; Yang, X.; Cao, H.; Li, J.; Cao, P.; Guo, L.; Wang, X.; Zhao, J.; Xiang, W. Alternaria spp. associated with leaf blight of Maize in Heilongjiang Province, China. Plant Dis. 2021, 106, 572–584. [Google Scholar] [CrossRef]
- Li, J.; Zhang, R.Y.; Wang, X.Y.; Shan, H.L.; Wang, C.M.; Cang, X.Y.; Huang, Y.K. First Report of Alternaria tenuissima causing leaf blight on sugarcane in China. Plant Dis. 2020, 105, 1222. [Google Scholar] [CrossRef]
- Zhao, S.; Shamoun, S.F. Effects of culture media, temperature, pH, and light on growth, sporulation, germination, and bioherbicidal efficacy of Phoma exigua, a potential biological control agent for salal (Gaultheria shallon). Biocontrol Sci. Technol. 2006, 16, 1043–1055. [Google Scholar] [CrossRef]
- Tulukoğlu-Kunt, K.S.; Özden, M.; Di Francesco, A. Exploring wild and local fruits as sources of promising biocontrol agents against Alternaria spp. in apples. Horticulturae 2023, 9, 1156. [Google Scholar] [CrossRef]
- da Cruz Cabral, L.; Delgado, J.; Patriarca, A.; Rodriguez, A. Differential response to synthetic and natural antifungals by Alternaria tenuissima in wheat simulating media: Growth, mycotoxin production and expression of a gene related to cell wall integrity. Int. J. Food Microbiol. 2019, 292, 48–55. [Google Scholar] [CrossRef] [PubMed]
- Abbas, E.; Osman, A.; Sitohy, M. Biochemical control of Alternaria tenuissima infecting post-harvest fig fruit by chickpea vicilin. J. Sci. Food Agric. 2020, 100, 2889–2897. [Google Scholar] [CrossRef] [PubMed]
- Wang, Y.; Sun, Y.; Han, L.; Zhang, X.; Feng, J. Potential use of cuminic acid as a botanical fungicide against Valsa mali. Microb. Pathog. 2017, 106, 9–15. [Google Scholar] [CrossRef] [PubMed]
- Yoon, M.Y.; Cha, B.; Kim, J.C. Recent trends in studies on botanical fungicides in agriculture. Plant Pathol. J. 2013, 29, 1–9. [Google Scholar] [CrossRef]
Disclaimer/Publisher’s Note: The statements, opinions and data contained in all publications are solely those of the individual author(s) and contributor(s) and not of MDPI and/or the editor(s). MDPI and/or the editor(s) disclaim responsibility for any injury to people or property resulting from any ideas, methods, instructions or products referred to in the content. |
© 2024 by the authors. Licensee MDPI, Basel, Switzerland. This article is an open access article distributed under the terms and conditions of the Creative Commons Attribution (CC BY) license (https://creativecommons.org/licenses/by/4.0/).